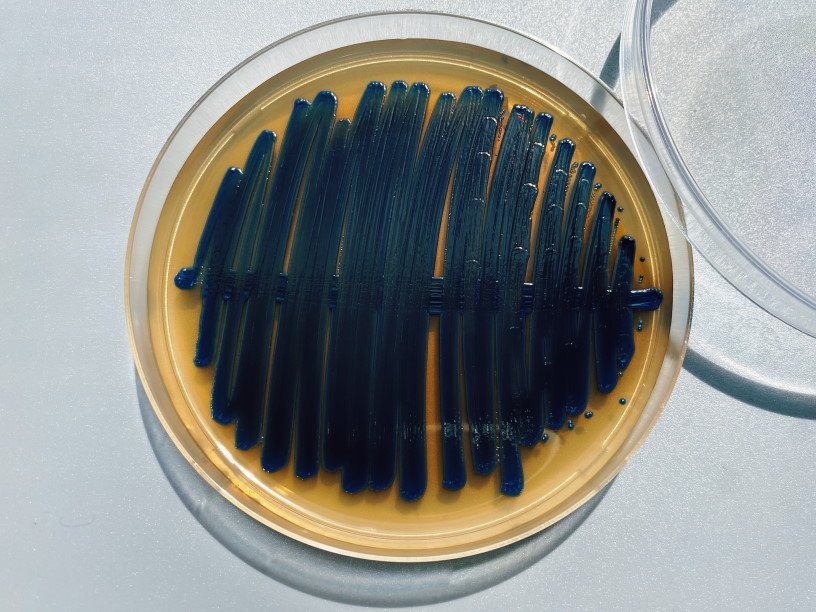

Екатерина Беленко: Промикробы: Техногенная катастрофа
Фото: Екатерина Беленко Есть такая организация — Американский легион. Созданная ещё после Первой мировой, она оказывает помощь американским ветеранам войн и является крупнейшей организацией военнослужащих. Как и любое объединение людей, они проводят всякие мероприятия и съезды. Вот в июле 1976 года в Филадельфию прибыло аж более 4000 участников такого съезда. Всё прошло гладко, люди разъехались по домам, но через три дня после окончания мероприятия один из участников скоропостижно скончался от заболевания, похожего на пневмонию. Ещё через пару-тройку дней врач обнаружил связь трёх своих пациентов с пневмонией и съезда Американского легиона. Всего во время этой вспышки заболел 221 человек, из них 34 скончались.
⠀
Впервые грамотрицательная палочка, отнесённая к роду Legionella, была выделена Джозефом Мак-Дейдом и Чарльзом Шепардом в 1977 году, через полгода после описанной вспышки. Бактерия была высеяна с фрагмента лёгкого погибшего от легионеллёза человека. Вспышку заболевания, по мнению учёных, спровоцировали колонии легионелл, размножавшиеся в жидкости вентиляционной системы, установленной в гостинице, где остановились участники съезда. Если вы сейчас испытали непреодолимое желание вызвать мастера по очистке кондиционеров — это нормально, я с вами. Вспышки странных пневмоний, конечно, случались и до этого. Многие из них переосмыслили и переизучили после открытия возбудителя легионеллёза. По некоторым даже смогли вынести вердикт, что это та самая палочка виновата.
⠀
Самый интересный случай произошёл в 1968 году в поликлинике города Понтиак, что в штате Мичиган. Заболевание, поразившее людей, кардинально отличалось от того недуга, который произошёл в Филадельфии в 1976 году, несмотря на то, что оказалось вызвано тем же самым микроорганизмом. Это заболевание получило название «понтиакская лихорадка», оно используется до сих пор для обозначения одной из форм легионеллёза. Несмотря на то, что симптомы поражения дыхательной системы отмечались и в Филадельфии, и в Понтиаке, не было зафиксировано ни единого случая развития пневмонии во время понтиакской вспышки. Летальных исходов от понтиакской лихорадки не отмечалось. Понтиакская лихорадка, в отличие от других форм легионеллёза, протекает как гриппоподобное заболевание, не приводит к тяжелым последствиям, пациент спонтанно выздоравливает, и поэтому болезнь часто не диагностируется.
⠀
Главным местом обитания легионелл являются объекты окружающей среды — пресные водоёмы и почва. Оптимальная для размножения легионелл температура внешней среды — это 25–42 °C. Но получается, что наряду с естественной нишей, где обитают легионеллы, существует и искусственная ниша, а именно рукотворные водные системы, где циркулирует вода оптимальной для них температуры. В таких системах создаются условия для образования в воздухе мелкодисперсного бактериального аэрозоля. Таким образом, легионеллёз является ещё и техногенной инфекцией. На распространение легионелл оказывает влияние климат, ну, а в случае «одомашненных» микробиков даже климат не важен. Больше всего случаев легионеллёза обнаруживается в США и Европе, но, видимо, это скорее говорит о высокой доступности более точных методов диагностики.
⠀
Проникновение возбудителя в организм происходит при вдыхании водных аэрозолей — помогут в этом душ, кондиционеры, увлажнители воздуха, фонтаны. Легионеллы могут жить в организме амёб. Так, например, установлено, что при той самой вспышке болезни легионеров в 1976 году через систему кондиционирования в вохдух попали именно амёбы, содержащие патогенные бактерии. Яйцо в утке, утка в зайце. Союз легионелл и простейших такой прочный и бактерия так обленилась, что в частности, Legionella pneumophila не может синтезировать аминокислоты цистеин, аргинин, изолейцин, лейцин, валин и треонин и получает их из организма хозяина.
Смотрите также: Екатерина Беленко Промикробы: С широко открытыми глазами Екатерина Беленко Промикробы: Ода кишечной микрофлоре Екатерина Беленко Среда для микробиологов Екатерина Беленко Микробы, они везде